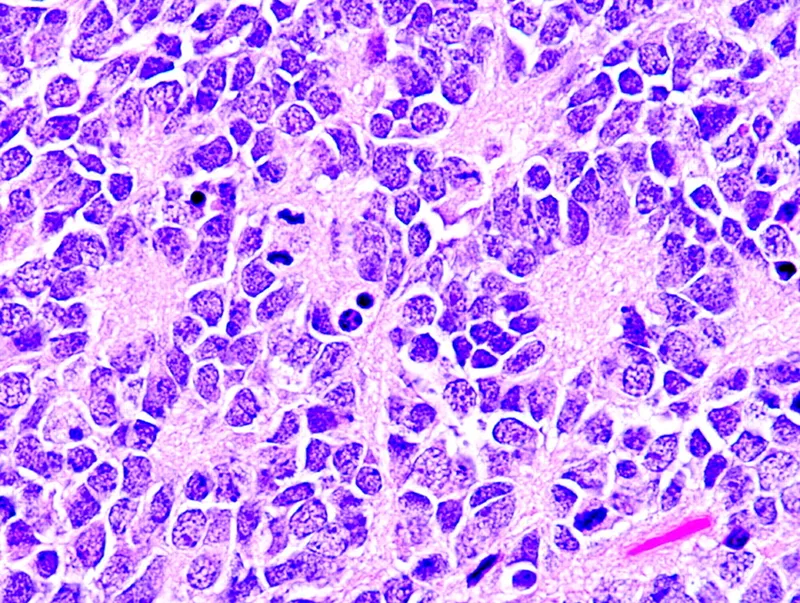
Neuroblastoma histology with Homer-Wright pseudorosettes

Adrenal Medulla Overview - Catecholamine Factory
- Origin: Neural crest cells (neuroectoderm).
- Cells: Chromaffin cells (modified postganglionic sympathetic neurons).
- Hormones: Synthesizes and secretes catecholamines:
- Epinephrine (Adrenaline) - ~80%
- Norepinephrine (Noradrenaline) - ~20%
- Dopamine (trace amounts)
- Regulation: Stimulated by acetylcholine from preganglionic sympathetic fibers.
⭐ The enzyme Phenylethanolamine N-methyltransferase (PNMT), crucial for converting norepinephrine to epinephrine, is induced by cortisol from the adrenal cortex. This highlights the cortico-medullary interaction.
Pheochromocytoma - Adrenaline Rush Hour
- Neuroendocrine tumor of chromaffin cells (adrenal medulla; or extra-adrenal paraganglia e.g., organ of Zuckerkandl). Secretes catecholamines (mainly Norepinephrine, Epinephrine).
- Clinical: Episodic "PHE" triad - Palpitations, Headache, Episodic sweating. Severe, paroxysmal hypertension is characteristic.
- 📌 Rule of 10s (classic): 10% extra-adrenal, 10% bilateral, 10% malignant, 10% pediatric, 10% familial. (Note: familial incidence now considered higher, ~25% or more with genetic testing).
- Diagnosis:
- Biochemical: ↑ Plasma free metanephrines (most sensitive test) OR ↑ 24-hr urinary fractionated metanephrines & catecholamines. Vanillylmandelic acid (VMA) is less specific.
- Imaging: CT/MRI of abdomen/pelvis to localize tumor. MIBG (¹²³I-metaiodobenzylguanidine) scan for extra-adrenal sites or suspected metastases.
- Associated Syndromes: Multiple Endocrine Neoplasia (MEN) 2A & 2B, Von Hippel-Lindau (VHL) disease, Neurofibromatosis type 1 (NF1), Succinate Dehydrogenase (SDHx) gene mutations.
- Management:
- Pre-operative: α-adrenergic blockade (e.g., phenoxybenzamine) for 10-14 days to control blood pressure and allow for volume expansion, followed by β-blockers (e.g., propranolol) if tachycardia develops (ONLY after adequate α-blockade).
- Definitive: Surgical resection of the tumor.

⭐ Pre-operative α-adrenergic blockade (e.g., phenoxybenzamine) is essential to prevent life-threatening hypertensive crisis during surgery due to catecholamine release on tumor manipulation.
Paraganglioma - Pheo's Wild Cousin
- Extra-adrenal neuroendocrine tumors from paraganglia (neural crest).
- Locations:
- Sympathetic chain (abdomen - organ of Zuckerkandl, thorax): Catecholamine-secreting.
- Head/Neck (carotid body, glomus): Often non-secretory; mass effects, CN palsies.
- Symptoms (if secreting): Episodic HTN, palpitations, headache, sweating.
- Diagnosis: ↑ metanephrines (plasma/urine); CT/MRI, MIBG scan.
- Genetics: High hereditary link (e.g., SDHx, VHL, RET mutations).
⭐ ~30-40% of paragangliomas/pheochromocytomas are hereditary.
Neuroblastoma - Kiddo's Neural Crest Crisis
- Most common extracranial solid childhood tumor; median age 18-24 months.
- Origin: Neural crest cells (adrenal medulla/sympathetic ganglia).
- Key Gene: N-MYC amplification (poor prognosis).
- Presentation: Abdominal mass (most common), pain, fever.
- Opsoclonus-myoclonus syndrome ("dancing eyes-feet").
- Blueberry muffin rash (skin mets).
- Diagnosis: ↑ urine VMA/HVA; biopsy shows small, round, blue cells, Homer-Wright pseudorosettes.
- Favorable Prognosis: Age < 18 months, no N-MYC amp, Stage 4S (infants <1yr, specific mets).
⭐ Spontaneous regression is a unique feature, especially in infants or Stage 4S disease.
High‑Yield Points - ⚡ Biggest Takeaways
- Pheochromocytoma: Most common adult adrenal medullary tumor; presents with episodic headaches, sweating, tachycardia.
- Diagnose pheochromocytoma via ↑ plasma/urinary metanephrines and catecholamines (VMA).
- Strong association with MEN 2A/2B, VHL, NF1 syndromes.
- Pre-operative management: alpha-blockers (e.g., phenoxybenzamine), then beta-blockers before surgery.
- Neuroblastoma: Commonest extracranial solid childhood tumor; features ↑ urinary HVA/VMA.
- Neuroblastoma: Homer-Wright pseudorosettes on histology; N-myc amplification signifies poor prognosis.
- Pheochromocytoma Rule of 10s: ~10% malignant, bilateral, extra-adrenal_._
Unlock the full lesson and continue reading
Signup to continue reading this lesson and unlimited access questions, flashcards, AI notes, and more